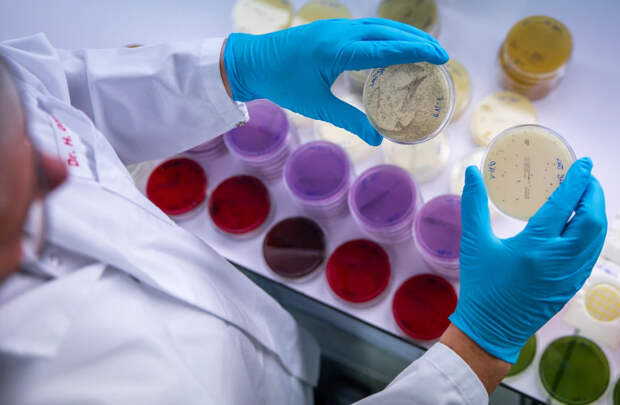

Исследование ученых показало, что бактерии, попадающие из кишечника в мозг, могут воздействовать на сон
Учёные в очередной раз доказали, что микробиом играет важную роль в нормальном функционировании организма. В частности, он влияет на сон, а точнее ночной отдых могут нарушить бактерии, которые попадают из кишечника в мозг, сообщает "Новая наука".
Пептидогликан, компонент клеточных стенок бактерий в пищеварительной системе, может проникать в центральную нервную систему и влиять на поведение человека. В связи с этими данными ученые провели опыты на мышах, в результате которых им удалось установить изменяющиеся параметры пептидогликана в мозге в течение дня – минимальный уровень приходится на утренние часы.
Исследователи также отметили, что если животным не давать спать, то состав пептидогликана в разных отделах мозга отличается от обычного уровня. Кроме того, меняется активность генов. Ученые сделали выводы, что бактерии из кишечника вырабатывают вещества, влияющие на сон.
Свежие комментарии